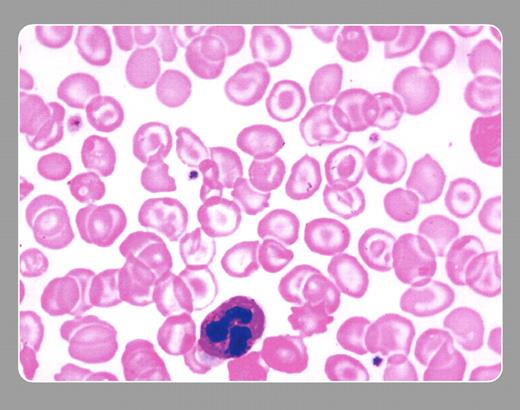
Neil Abramson, Baptist Cancer Institute

A 43-year-old white lawyer was referred for thrombocytopenia with no history of bruising or bleeding. He was a smoker who denied alcohol consumption and the use of drugs and medications. His spleen was palpable. The family history was negative for hematologic problems. Laboratory values included a platelet count of 70 × 109/L, hemoglobin of 111 g/L, and a normal white blood cell count. The peripheral smear affirmed the moderately decreased platelet count, but many targeted red cells were also noted. Target cells are seen in a number of disorders, both inherited (hemoglobin C, thalassemia, sickle cell disease, et cetera) and acquired (usually liver disease). When pressed about the possibility of liver disease because of target cells and an enlarged spleen, the patient reluctantly admitted to excessive alcohol consumption. Liver enzymes were mildly elevated. The hemoglobin electrophoresis and reticulocyte count were normal, and Coombs test, antinuclear antibodies, and rheumatoid antibody were negative.
Thrombocytopenia that is associated with liver disease (portal hypertension) is often caused by nonimmune sequestration by an enlarged spleen. In this patient's case, the target red cells directed the investigation to the diagnosis.
Many Blood Work images are provided by the ASH IMAGE BANK, a reference and teaching tool that is continually updated with new atlas images and images of case studies. For more information or to contribute to the Image Bank, visit www.ashimagebank.org.